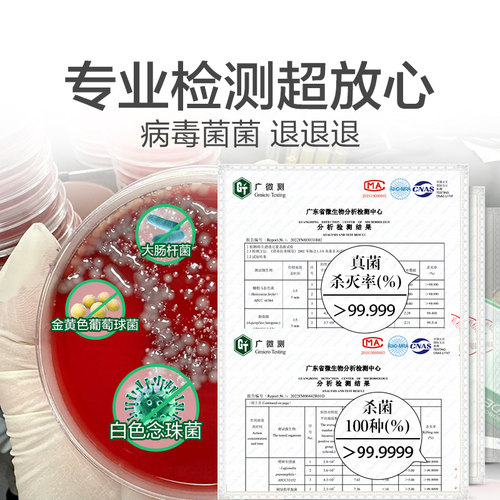
【自营】滴露消毒液家用洗衣消毒水衣物杀菌地板拖地灭活hpv16 - 图1

【自营】滴露消毒液家用洗衣消毒水衣物杀菌地板拖地灭活hpv16
滴露消毒液1.8L家用杀菌消毒
店铺:天猫国际自营全球超级店 品牌:Dettol/滴露 地址:浙江 杭州 商城:天猫

店铺:天猫国际自营全球超级店 品牌:Dettol/滴露 地址:浙江 杭州 商城:天猫
 洗护清洁剂/卫生巾/纸/香薰
89.92
满件折
洗护清洁剂/卫生巾/纸/香薰
89.92
满件折
天猫好物 Dettol/滴露
优惠22.48元 洗护清洁剂/卫生巾/纸/香薰
25.9
低价
洗护清洁剂/卫生巾/纸/香薰
25.9
低价
淘宝好物 瑞泰奇
购买 洗护清洁剂/卫生巾/纸/香薰
17.8
折扣
洗护清洁剂/卫生巾/纸/香薰
17.8
折扣
销量17 GNCE/佳尼斯
购买 洗护清洁剂/卫生巾/纸/香薰
9.9
券后价
洗护清洁剂/卫生巾/纸/香薰
9.9
券后价
淘宝好物 衡洁
2元优惠券 洗护清洁剂/卫生巾/纸/香薰
130
券后价
洗护清洁剂/卫生巾/纸/香薰
130
券后价
天猫好物 爱特福84
5元优惠券 洗护清洁剂/卫生巾/纸/香薰
13.9
折扣
洗护清洁剂/卫生巾/纸/香薰
13.9
折扣
天猫好物 Abajo/阿巴乔
购买 洗护清洁剂/卫生巾/纸/香薰
21.8
券后价
洗护清洁剂/卫生巾/纸/香薰
21.8
券后价
淘宝好物 天罡
2元优惠券 洗护清洁剂/卫生巾/纸/香薰
25.8
折扣
洗护清洁剂/卫生巾/纸/香薰
25.8
折扣
淘宝好物 爱特福84
购买 有效杀灭99%
80.9
券后价
有效杀灭99%
80.9
券后价
天猫好物 Cleafe/净安
5元优惠券 有效杀灭活病毒 德国DPL核心杀毒技术
15.99
折扣
有效杀灭活病毒 德国DPL核心杀毒技术
15.99
折扣
天猫好物 雪雅洁
购买